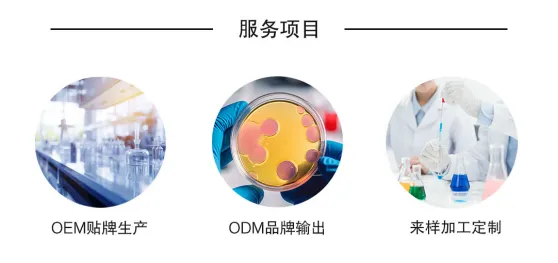
图片

- 我的门票
- 我的展会
- 我的行业
- 网站地图
- 登录/注册
江西登特科技有限公司与您相约2025年11月05-07日PCE上海口腔用品展
· 点击上方图片,一键Get逛展门票!
展位号:E2-F026
江西登特科技有限公司是一家集研发、生产、销售于一体的口腔医疗行业领军企业,已通过ISO13485质量管理体系认证、ISO22716质量管理体系认证、美国GMP质量管理体系认证、美国BSCI商业社会责任标准认证以及中国医疗器械体系认证的公司。我司先后荣获2018年“高新技术企业”、2021年江西省"专精特新中小企业”以及“2021全国成长型企业创新创业大赛优秀奖”等荣誉。

公司一贯秉承“以技术创新引领市场”的理念扎根深耕口腔行业。拥有1000㎡研发中心,11人的研发团队以及微生物检测实验室及美白效果检测等设备50余台;公司长期与南昌大学、江西师范大学开展产学研合作,为快速开发新产品及满足客户定制需求提供了有力的技术支持。我司秉承“以技术创新引领市场”的理念,深耕口腔行业,目前已有海内外专利38项,多项研究成果发表于国际SCI期刊,科技成果已转化为我司核心竞争力。

江西登特科技有限公司专业从事牙齿美白产品,主营产品有牙齿美白套装、牙齿美白贴、牙齿美白仪、牙齿美白粉、牙齿美白凝胶、硅橡胶口腔印模材、牙膏粒、口喷以及漱口水等口腔系列产品,产品远销海内外91个国家及地区,服务全球7000余名客户。牙齿美白仪、牙齿美白凝胶通过三甲医院临床实验并获得中国医疗器械二类产品注册证;硅橡胶口腔印膜材获得美国药监局FDA (510K)产品注册证和欧洲医疗器械MDR指令下CE认证。

工厂占地面积超45,000平方米,其中90%属于十万级无尘净化车间。我司现有200多名员工,80多台专业生产设备及十余条自动化生产线。
国际证书
江西登特科技有限公司产品获得了美国FDA、欧洲CE、英国UKCA、HALAL清真证书、Vegan素食证、WEEE、ROHS、REACH、CPSR等认证。

OEM/ODM/品牌代理
一站式个性服务
致力成为最值得信赖的全球供应商

登特集团 成为最值得信赖的全球供应商
视频号:登特集团
:登特集团
官网1:www.glorysmile.com
官网2:www.enjoywhite.com
参考资料:
PCE举办地址:上海市浦东新区龙阳路2345号
展览面积:23000㎡
观众数量:25000
















